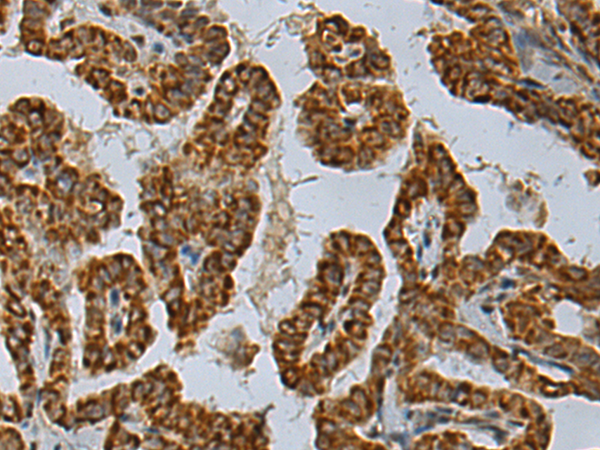
一抗

技術(shù)規(guī)格
|
Background: |
Removes ADP-ribose from asparatate and glutamate residues in proteins bearing a single ADP-ribose moiety (PubMed:23474714, PubMed:23474712). Inactive towards proteins bearing poly-ADP-ribose (PubMed:23474714, PubMed:23474712). Deacetylates O-acetyl-ADP ribose, a signaling molecule generated by the deacetylation of acetylated lysine residues in histones and other proteins (PubMed:21257746). Plays a role in estrogen signaling (PubMed:17893710, PubMed:17914104, PubMed:19403568). Binds to androgen receptor (AR) and amplifies the transactivation function of AR in response to androgen (PubMed:19022849). May play an important role in carcinogenesis and/or progression of hormone-dependent cancers by feed-forward mechanism that activates ESR1 transactivation (PubMed:17893710, PubMed:17914104). Could be an ESR1 coactivator, providing a positive feedback regulatory loop for ESR1 signal transduction (PubMed:17914104). Could be involved in invasive growth by down-regulating CDH1 in endometrial cancer cells (PubMed:17893710). Enhances ESR1-mediated transcription activity (PubMed:17914104). |
|
Applications: |
ELISA, IHC |
|
Name of antibody: |
MACROD1 |
|
Immunogen: |
Fusion protein of human MACROD1 |
|
Full name: |
mono-ADP ribosylhydrolase 1 |
|
Synonyms: |
LRP16 |
|
SwissProt: |
Q9BQ69 |
|
ELISA Recommended dilution: |
5000-10000 |
|
IHC positive control: |
Human breast cancer and Human thyroid cancer |
|
IHC Recommend dilution: |
100-300 |


 購(gòu)物車
購(gòu)物車 幫助
幫助
 021-54845833/15800441009
021-54845833/15800441009